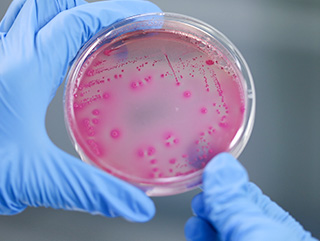

導航
 微生物檢測
微生物檢測
2007年4月12日,在廣西壯族自治區銷售的某著名品牌云吞及水餃被檢出金黃色葡萄球菌。這一檢測結果公布之后,商家采取措施,對購買到問題批次產品的消費者提供退貨服務。衛生監督部門對銷售問題產品的超市進行立案查處,對已經發現問題批次的產品進行銷毀,并向產品生產企業所在地的衛生監督部門發出協查函,同批次產品全部下架和召回,并且對外公布了不合格產品名單。
微生物指標是衡量食品安全常見、重要的因素之一。食品如果含有超出一定數量的微生物,不僅會使食物變質、腐敗、失去營養價值,而且還會危害人類的健康和安全。中安檢測可以依據國家標準及食品行業公認的國內外權威的標準方法提供多種微生物測試項目,并為客戶提供特定的檢測方法以驗證微生物安全性與產品質量。
微生物檢測項目
檢驗項目 | 項目內容 |
非致病性菌 | 菌落總數、大腸菌群、大腸埃希氏菌、乳酸菌、霉菌和酵母菌等 |
食源性致病菌 | 大腸埃希氏菌O157:H7,沙門氏菌,志賀氏菌,金黃色葡萄球菌,溶血性鏈球菌,單核細胞增生李斯特氏菌,副溶血性弧菌、產氣莢膜梭菌、阪崎腸桿菌檢驗、蠟樣芽胞桿菌、銅綠假單胞菌等 |
其它 | 大腸埃希氏菌O157:H7、沙門氏菌、志賀氏菌、金黃色葡萄球菌、單核細胞增生李斯特氏菌、副溶血性弧菌、產氣莢膜梭菌、阪崎腸桿菌、蠟樣芽胞桿菌、銅綠假單胞菌等 |
1、食品農產品領域CNAS,CMA,CATL資質認定認可指標超過4000余項,覆蓋領域95%以上測試項目,為了減少您多處送檢的困擾
2、食品農產品領域由博士、高級工程師等技術專家領銜的技術團隊總人員數已超100人,為了給您提供更專業的檢測、認證、咨詢、培訓一站式服務
3、我們致力不斷優化以質量、價格、流程、渠道為核心的技術服務產品,為了給您尤佳的檢測服務體驗
資質:CNAS、CMA、CATL


電話: 028-87896611/028-87896622

郵箱: zatest@mxns.cn

手機:18908103450

報價申請: ??點擊即可報價申請??

QQ: 點擊在線聯系
Sichuan Safety Testing Center Co.,LTD. 四川省中安檢測有限公司 版權所有 蜀ICP備15017687號

服務領域